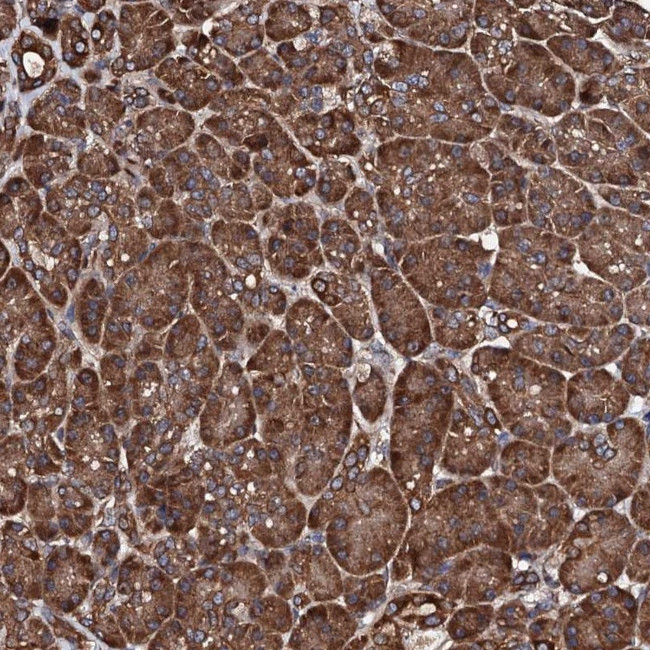
CKAP5 Antibody in Immunohistochemistry (Paraffin) (IHC (P))

Search
Invitrogen
CKAP5 Polyclonal Antibody
{{$productOrderCtrl.translations['antibody.pdp.commerceCard.promotion.promotions']}}
{{$productOrderCtrl.translations['antibody.pdp.commerceCard.promotion.viewpromo']}}
{{$productOrderCtrl.translations['antibody.pdp.commerceCard.promotion.promocode']}}: {{promo.promoCode}} {{promo.promoTitle}} {{promo.promoDescription}}. {{$productOrderCtrl.translations['antibody.pdp.commerceCard.promotion.learnmore']}}
产品信息
PA5-58763
种属反应
已发表种属
宿主/亚型
分类
类型
抗原
偶联物
形式
浓度
规格
纯化类型
保存液
内含物
保存条件
运输条件
RRID
产品详细信息
Immunogen sequence: WKARLSGYEE ALKIFQKIKD EKSPEWSKFL GLIKKFVTDS NAVVQLKGLE AALVYVENAH VAGKTTGEVV SGVVSKVFNQ PKAKAKE
Highest antigen sequence identity to the following orthologs: Mouse - 99%, Rat - 26%.
靶标信息
Colonic and hepatic tumor over-expressed protein (ch-TOG) belongs to the TOG/XMAP215/Dis1 evolutionarily ancient family of microtubule-associated proteins with isoforms found in all major kingdoms of eukaryotes. This protein is required for the assembly and function of the meiotic or mitotic spindles during cell division and is localized to microtubule-organizing centers (MTOCs) during interphase or to the spindle poles and centrosomes during mitosis or cytokinesis.
仅用于科研。不用于诊断过程。未经明确授权不得转售。
生物信息学
蛋白别名: Ch-TOG; ch-TOGp; colonic and hepatic tumor over-expressed gene protein; Colonic and hepatic tumor overexpressed gene protein; Cytoskeleton-associated protein 5; unnamed protein product
基因别名: ch-TOG; CHTOG; CKAP5; KIAA0097; MSPS; TOG; TOGp
UniProt ID: (Human) Q14008
Entrez Gene ID: (Human) 9793